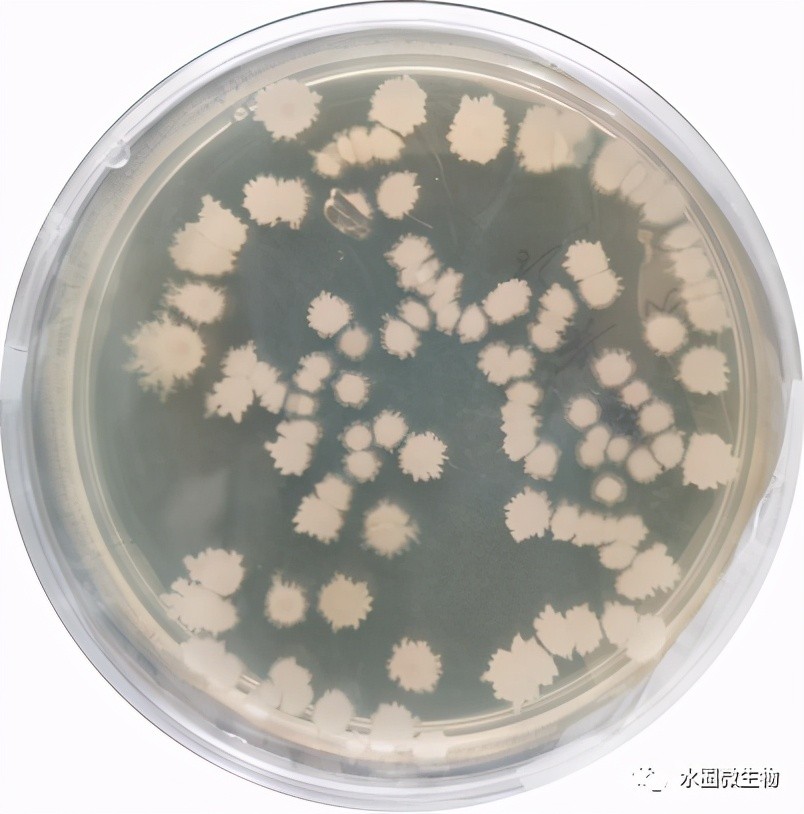

菌中之王——枯草芽孢杆菌
菌中之王——枯草芽孢杆菌
简介
枯草芽孢杆菌(Bacillus subtilis)是一种嗜温、好氧、产芽孢的杆状细菌,其生理特征多样,分布广泛,极易分离培养。该菌在自然界中广泛存在,不仅可以在土壤、植物根际体表等外界环境中广泛存在,而且是植物体内常见内生细菌,尤其是在植物的根、茎部。由于其易在枯草浸汁中繁殖,故而得名“枯草芽孢杆菌”。目前该菌已经在水稻、大豆、棉花、小麦、辣椒、番茄、玉米等农作物上显示出很好的病害防治效果。
1835年Ehrenberg发现枯草芽孢杆菌,并将其命名为“Vibrio subtilis”。1872年随着细菌分类系统的建立,Cohn又将其命名为“Bacillus subtilis”。1997年,Kunst F.等人首先完成了枯草芽孢杆菌的完整基因组序列测定,并将结果发表在《Nature》杂志上。

枯草芽孢杆菌单个细胞0.7-0.8×2-3微米,着色均匀。无荚膜,周生鞭毛,能运动。革兰氏阳性菌,可形成内生抗逆芽孢,芽孢0.6-0.9×1.0-1.5微米,椭圆到柱状,位于菌体中央或稍偏,芽孢形成后菌体不膨大。生长、繁殖速度较快,菌落表面粗糙不透明,污白色或微黄色,在液体培养基中生长时,常形成皱醭,是一种需氧菌。
枯草芽孢杆菌菌落形态图

-
- 广东省中山市概况
-
2025-12-20 06:37:29
-
- 空客A350双发宽体远程客机
-
2025-12-20 06:35:15
-
- 韩国灾难片《釜山行》病毒入侵 首曝剧照
-
2025-12-20 06:33:00
-
- 西宁野生动物园营业时间变更,请查收
-
2025-12-20 06:30:46
-
- 收藏!故宫蛇年初雪壁纸来了
-
2025-12-20 06:28:32
-
- 如果你体重超过140斤,建议避开这些显胖颜色,不用减肥也能瘦
-
2025-12-20 06:26:17
-
- 常见观赏鱼——招财猫鱼
-
2025-12-20 06:24:03
-
- 项羽的爹是谁?是不是项少龙?答案显而易见啊
-
2025-12-20 06:21:49
-
- 什么是权威?
-
2025-12-20 01:32:14
-
- 强推,绝对宝藏文,强推《云胡不喜》
-
2025-12-20 01:30:00
-
- 罕见老照片:"香帅" 郑少秋年轻时真是风流倜傥,玉树临风
-
2025-12-20 01:27:46
-
- 地铁实力大比拼,近日中国地铁最厉害的城市排名出炉
-
2025-12-20 01:25:31
-
- 【随侯珠】作品合集!14本等你来刷《时间都知道》《别那么骄傲》
-
2025-12-20 01:23:18
-
- 雅马哈天王250,小排量太子车霸主
-
2025-12-20 01:21:03
-
- 三国武将排行榜,三国前七十八名武将排行一览
-
2025-12-20 01:18:48
-
- 卡塔尔世界杯32强巡礼 |“桑巴军团”巴西
-
2025-12-20 01:16:34
-
- 挪威的首都---------奥斯陆
-
2025-12-20 01:14:19
-
- 附睾丸囊肿的症状体征
-
2025-12-20 01:12:06
-
- 寸头是最有男性荷尔蒙的发型!不管你是什么脸型都该尝试一次寸头
-
2025-12-19 19:39:10
-
- 2018年浙江省公务员招考|省级单位职位表(含紧缺职位)
-
2025-12-19 19:36:55



轩尼诗洋酒6斤价格表(轩尼诗洋酒是什么酿造的)
男人为什么喜欢被口爱 被口时候到底有多舒服
男人对女人开黄腔是什么意思,是在试探女人吗
铝合金高压锅对人体有害吗 铝合金高压锅对人体有害吗知乎
从大连到鲅鱼圈多少公里 大连至鲅鱼圈多少公里
男女对视十秒定律是什么,为什么男女对视不能超过十秒
利仁电饼铛电路图电饼铛开关接线图
骞怎么读(蹇、謇、骞、搴、褰--汉字五兄弟分享给大家)
山东省李姓的祖先 山东姓李的辈分排列顺序
屠神者格尔的实力是什么级别